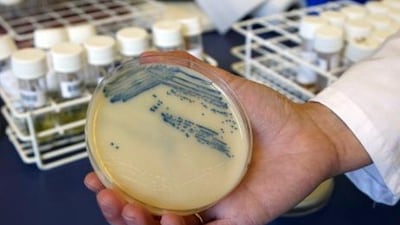
A petri dish with methicillin-resistant Staphylococcus aureus (MRSA). Incidences of the superbug are on the rise in the UAE.

ABU DHABI // MRSA, the bacterium that resists antibiotics and is a leading cause of potentially fatal infections, is on the rise in hospitals.
A study at Tawam Hospital in Al Ain found the superbug was more than twice as prevalent in 2008 than in 2003. Health experts said the findings were likely to be repeated throughout the country, and urged tighter hospital infection control procedures, improved hygiene and a curb on unnecessary prescriptions for antibiotics.
“This is actually why we are trying to control the prescription of antibiotics,” said Dr Omniyat Al Hajeri, the director of public health and policy at the Health Authority-Abu Dhabi.
“Not everybody that has the common cold or the flu should be prescribed an antibiotic until it is clearly evident that they have a secondary bacterial infection.”
Staphylococcus aureus (S. aureus) is a bacterium that is often present in our skin and nostrils. It can cause a range of conditions, from minor infections to life-threatening illnesses such as pneumonia and meningitis, but can be successfully treated with antibiotics.
Healthy individuals may also carry the antibiotic-resistant strain (methicillin-resistant Staphylococcus aureus, or MRSA) with no ill effects. It is when they become ill or have an open wound that the bacterium becomes dangerous.
Researchers from UAE University studied 26 strains of MRSA at Tawam Hospital in 2003, and again in 2008. In 2003, the 26 MRSA bacteria were found in 500 strains of S. aureus, an incidence of 5.2 per cent. In 2008, the 26 MRSA were found in 211 strains of S. aureus, an incidence of 12.3 per cent.
“In this country, our MRSA cannot be compared with countries like the UK. We are more to be compared with Scandinavian countries, where it is much lower,” said Dr Mansour Al Zarouni, a medical and molecular microbiologist and the head of laboratories at Sharjah Medical District.
“So that’s good news, but the bad news is it is increasing for various reasons.”
These reasons could include a patient travelling abroad for treatment, picking up the bacterium, then bringing it back with them to the UAE, said the doctor.
S. aureus is a relatively common bacteria but it is also responsible for a range of conditions: from impetigo and abscesses to more serious illnesses such as meningitis and staphylococcal toxic shock syndrome (STSS). It is most commonly spread by a combination of lack of hand hygiene and direct contact – from patient to patient or from a healthcare worker to a patient.
The bacteria’s growing resistance to antibiotics such as methicillin is a threat to both patients and hospitals, said Professor Tibor Pal, one of the authors of the study and a consultant clinical microbiologist and professor of microbiology at UAE University’s faculty of medicine and health sciences.
“If the organism is resistant to methicillin it means that the Staphylococcus aureus strain is resistant to the whole class of beta-lactams [antibiotics], so a very important class of drugs is out; we can’t use them,” he said.
Although the UAE University study focuses on only one hospital, Dr Jens Thomsen, of the community health and surveillance department at the Health Authority-Abu Dhabi (Haad), said it was likely not to be an isolated incident.
“Antimicrobial resistance data is currently still being analysed on a pan-Emirates level and not by hospital. Preliminary results and findings are still subject to further analysis and expert discussion.
“There is, however, evidence that MRSA rates at several hospitals have increased significantly over the last years, compared to data published in the scientific literature.”
Community-Acquired MRSA (CA-MRSA), which differs from Hospital-Acquired MRSA (HA-MRSA) in that it is less resistant to antibiotics, is also on the increase in hospitals. At Tawam, over the same five-year period, CA-MRSA overtook HA-MRSA to comprise 73.1 per cent of the strains tested.
The rate at which MRSA grows resistant to antibiotics is likely to be affected by the overuse of these medicines, said Dr Al Hajeri.
“We get challenged all the time on why we are controlling the prescription of antibiotics. We get challenged by the community itself but we also get the challenge from general practitioners and most of the junior physicians that are in an outpatient setting,” she said.
The increase in MRSA found is not yet on par with that of other countries but it is a problem that must be looked at immediately, and with great importance, Dr Thomsen said.
“It is a concerning trend and they report in their study that this is a common finding in other hospitals as well. Over the whole UAE, it’s kind of a similar trend, so, of course, hospital infection control procedures have to be followed and strictly adhered to to combat this trend.”
ZAlhassani@thenational.ae